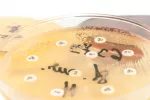

Posibles problemas del destete

Actualizado: 22 de septiembre de 2022
Los problemas del destete suelen ser una consecuencia de su implantación brusca; cuanto más dure, menos traumático será tanto para la madre como para el bebé. Esto es lo que puede conllevar en cada uno de ellos que el proceso no sea gradual:
Desventajas del destete para el bebé
Para el bebé una interrupción brusca de la lactancia puede originar inseguridad, miedo, sensación de falta de cariño y apego… El pecho no es sólo fuente de alimento, por lo que hay que recordar que la sustitución nutritiva y emocional deben ir siempre de la mano.
Inconvenientes para la madre
En definitiva, el destete es un proceso gradual para el que madre e hijo deben de estar preparados, sin cronología exacta en el tiempo, pese a la presión social y familiar (muchas veces por ignorancia) que pueden afectar a la madre si ésta decide mantener una lactancia prolongada.
Creado: 9 de enero de 2013